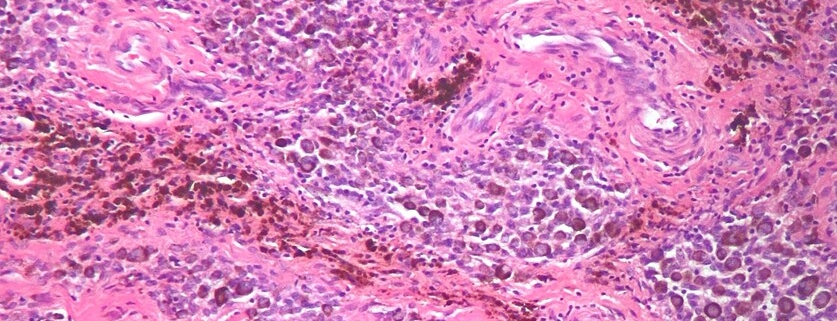

Pigmented Villonodular Synovitis of the Knee
Overview
Pigmented Villonodular Synovitis (PVNS) of the knee is a rare, benign condition involving the synovium, the thin layer of tissue lining your joints. It is characterized by the growth of small, pigmented nodules that can lead to pain, swelling and reduced mobility. Although this condition can occur at any age, it is most prevalent among individuals between the ages of 20 and 50.
Types
There are two types of PVNS: localized and diffuse. Localized PVNS typically only affects a small area inside the joint and symptoms are generally mild. On the other hand, diffuse PVNS is a more widespread form of the disease that affects a larger area and may cause more severe symptoms.
Causes
The exact cause of PVNS remains unknown. However, scientists believe the condition may be related to inflammation or trauma to the joint. Additionally, genetics may play a role as the condition has been found to run in some families.
Symptoms
The most common symptoms of Pigmented Villonodular Synovitis of the knee include:
-
- Pain and swelling in the affected knee.
-
- Limited range of motion.
-
- Stiffness or instability when walking.
-
- A feeling of warmth in the affected joint.
Less common symptoms might include joint locking or a crunching sensation in the joint.
Diagnosis
Diagnosis of PVNS incorporates a variety of tests, including:
-
- Physical examination: Doctors might palpitate your knee, checking for tenderness, swelling or limited movement.
-
- Imaging tests: X-rays, MRIs and ultrasounds can reveal abnormal growths in your knee.
-
- Biopsy: In some cases, doctors may conduct a biopsy, removing a small tissue sample from the knee to examine under a microscope.
Treatment Options
Treatment for PVNS focuses on managing pain, preserving the function of the knee, and preventing complications. Treatment may include:
-
- Non-surgical treatments, such as physical therapy, medication, joint aspiration, or radiation therapy.
-
- Surgery: This might involve arthroscopy (minimally invasive surgery using a tiny camera and small instruments), partial synovectomy (removal of part of the synovium), or total synovectomy (complete removal of the synovium).
Living With Pigmented Villonodular Synovitis of the Knee
Living with PVNS can feel challenging, but here are some helpful tips:
-
- Exercise: Regularly engage in low-impact activities like swimming or cycling, which can strengthen the muscles around the knee without causing further damage.
-
- Rest: Take regular breaks from physical activity to avoid overusing your knee joint.
-
- Pain management: Over-the-counter medication or prescribed drugs from your physician can help manage pain and inflammation.
-
- Adequate nutrition: Eating a balanced diet can potentially aid function and recovery.
When to Seek Help
If you’ve been diagnosed with PVNS and experience any of the following, it might be time to seek immediate medical help:
-
- Sudden, severe pain in your knee.
-
- Significant swelling or redness around the knee.
-
- An inability to bear weight on the affected leg.
It’s essential to maintain open communication with your physician about symptoms or changes in your condition to ensure the best possible outcome.